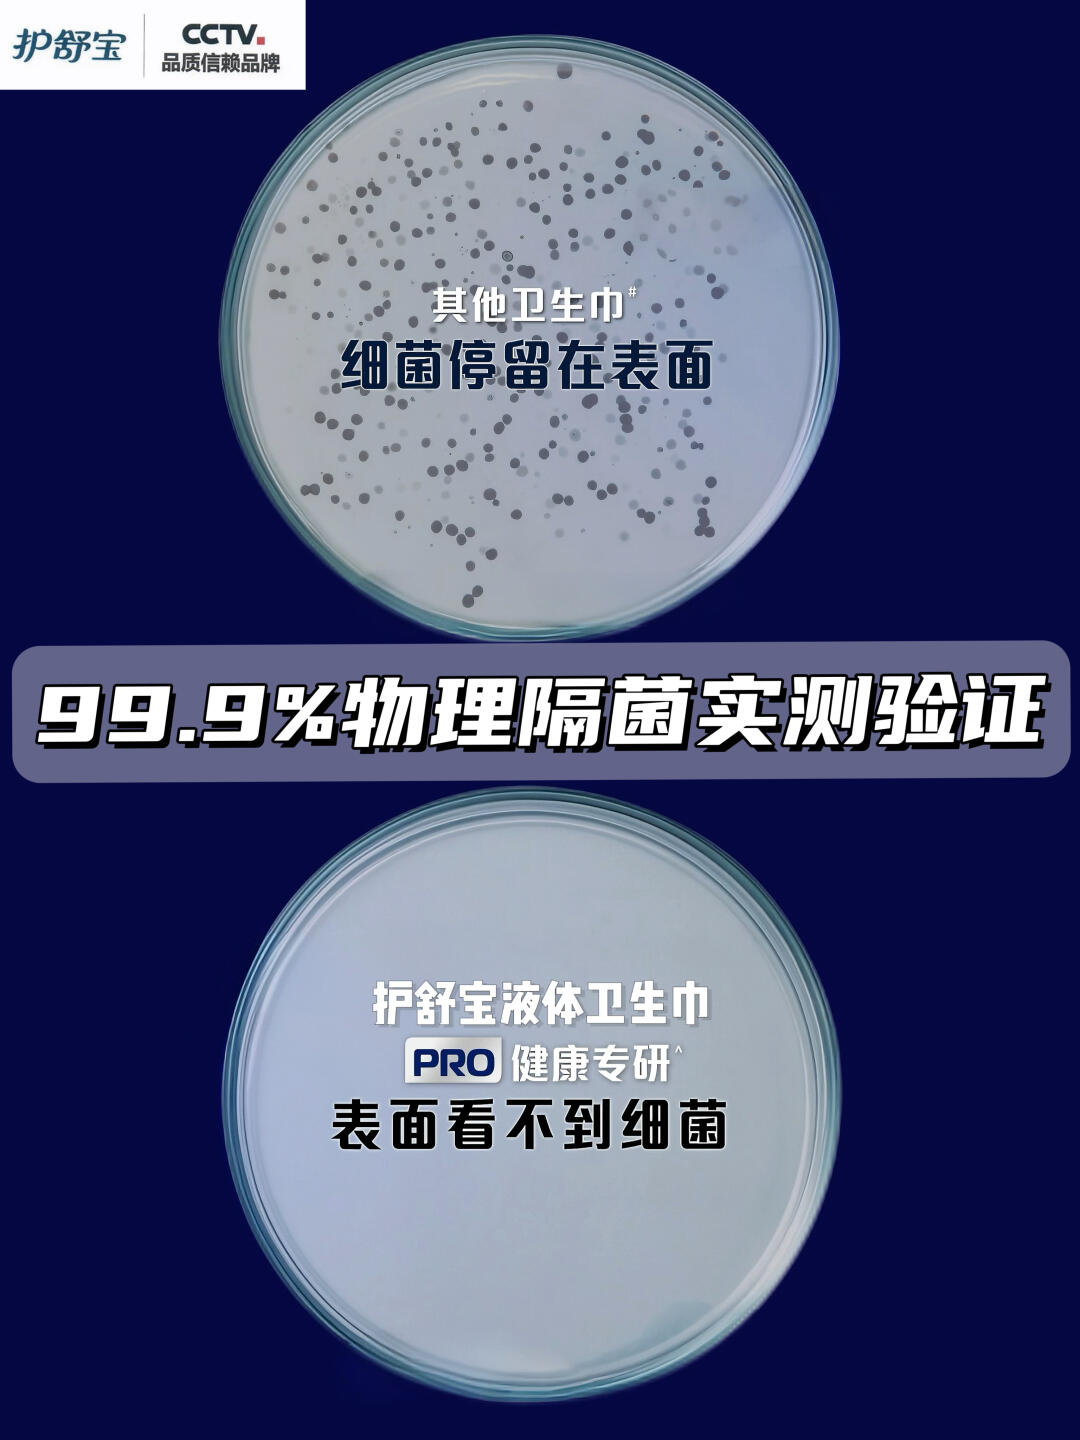

讲真,经期养生真的是一门学问
特别是量大的女生,每次生理期都堪比渡劫
不仅不敢大步走路!随便一动都感觉血如泉涌
而且就算两小时换一次卫生巾
都还是减少不了那种湿漉漉的闷潮黏腻!
有时候还会痒痒的
其实月经期间大部分的闷痒不适
都是由不断和皮肤亲密接触的经血带来的
能物理隔菌的卫生巾真的是上上解
但现实是卫生巾市场真的太乱了
像化学隔菌这样看上去很高级
实际一点用都没有噱头满天飞
真正静下心来做好物理隔菌的良心卫生巾太少了
本来都准备摆烂了
无意中换了👉🏻护舒宝液体卫生巾PRO健康专研
真的再也没让我感受过黏腻闷热还侧漏的苦
要给它磕两个响头!!
研究了一把才知道,这都要归功于它的
物理隔菌黑科技!
简单解释下就是,普通卫生巾吸完之后
经血仍然停留在能够接触到肌肤的表层
时刻和皮肤紧密接触,这样很容易滋生细菌
皮肤受到刺激就会产生闷痒感
而护舒宝PRO首创的99.9%物理隔菌黑科技
经血一渗出 就被瞬间隔开到卫生巾底部
让直接接触皮肤的卫生巾表层始终干爽
就像在经血细菌和皮肤中间建了个“物理隔菌盾”
从根源上解决了经期的闷痒不舒适
更让我惊喜的是
一般干爽度达到了,表面的柔软度就难以保证了
但PRO健康专研竟然直接干到了婴儿级认证
肤感细腻轻柔又亲肤
用下来的体感舒适度真的很高
真不愧是央妈都推荐的卫生巾!
真的想把它安利给所有女生
一起清爽舒适度过生理期~